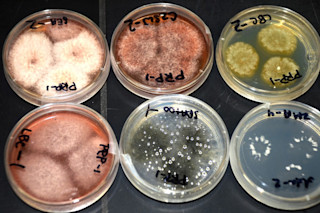

从土壤中制造药物(图片来源:C Coker, Cichewicz Lab)带您了解公民科学土壤采集计划的幕后和实验室
这是一篇客座文章,作者是 Robert H. Cichewicz 博士,他是俄克拉荷马大学教授,也是 公民科学土壤采集计划的负责人。Cichewicz 博士此前在 SciStarter 上撰写过关于如何参与该项目的文章。在这篇文章中,他描述了他在实验室里实际发生的幕后工作,这些工作帮助他们的团队(在您的帮助下!)发现可能对治疗疾病有用的真菌新化合物。对细菌和微生物感到好奇吗?在 SciStarter 上查看我们为您精选的更多微生物主题项目!
数千年来,我们的祖先将大地视为治愈各种疾病的源泉。例如,《埃伯斯纸草》(约公元前 1500 年在埃及附近写成)提供了数百种药用植物和矿物用于治疗包括疼痛、呕吐和感染在内的多种疾病的例子。快进到现代,我们看到研究疾病的研究方法发生了巨大变化,但大地是救命药物最佳来源的理念一直延续至今。我们的星球仍然蕴藏着许多现代疾病的秘密的理念,得到了大量不断增长的天然来源药物清单的支持。其中许多药物是由土壤中的细菌和真菌制造的。微生物已产生了多种重要的化合物(例如青霉素、他汀类药物和环孢素最初都来自真菌),用于治疗癌症和感染。但寻找这些有益的土壤微生物并将其转化为救命药物并非易事。这需要研究团队的合作,也需要像您这样的普通人的帮助。几周前,我写了一篇博文,邀请您参与这个过程,通过从您的后院寄送土壤样本成为一名公民科学家。我们收到了大量回复,收到了数千份样本,我们现在正在处理这些样本,希望能发现大自然隐藏的下一个惊人秘密。您可能会问自己:“在我寄出样本后,真正会发生什么?”或“您需要多长时间才能从我寄送的样本中发现什么?”为了回答这些问题并告诉您幕后发生的事情,我决定写这篇文章。系好安全带,让我带您踏上一段将一把泥土变成救命药物的旅程。第一步:从您的院子到我们的实验室 旅程始于您从我们的实验室申请免费的公民科学土壤采集套件。选择您家院子里的一个 favorite place,将少量土壤放入收集袋,封好,然后将包裹放入邮箱(我们已经为您支付了退货邮费!)。只需不到 5 分钟,而且我没提过它是免费的吗?第二步:从土壤中种植真菌

土壤样本在培养皿中展开以种植真菌(图片来源:C Coker, Cichewicz Lab)我们勤奋的学生和研究人员团队开始从您的样本中分离真菌。大多数土壤都富含多种微生物,包括真菌——这是新颖有用的药物状分子的绝佳来源。即使您看不到它们,您的样本中也可能含有数千种。我们将土壤铺在培养皿表面,培养皿中盛有浸有真菌食物的凝胶,其中包括土壤“茶”、打碎的蠕虫、简单糖和磨碎的番茄——美味!第三步:使用 DNA 测序鉴定真菌物种 在土壤样本中的真菌生长并分离后,下一步是使用基因序列信息鉴定新物种。隐藏在真菌 DNA 的广阔景观中有一小段基因物质,称为内部转录间隔区(ITS)。这种真菌“条形码”有助于我们区分不同的物种,识别新物种,或将它们归类到一个称为属的更大群体中。据估计,地球上约有 500 万种不同的真菌,但只有约 2% 被鉴定出来。考虑到这些几率,您的后院可能一直住着一种或多种您从未知道过的新型真菌!由于我们外展活动的响应非常棒,我们收到了数百份样本,这很好。但我们处理的样本量巨大,这意味着微生物学家可能需要一年或更长时间才能处理您的样本。但我们不会让您一无所知!我们将设置一个真菌相册,以便您可以看到从您的样本中分离出哪些真菌。请访问我们的网站获取更新!第四步:提取真菌化合物并在不同的疾病模型中进行测试

真菌最喜欢的食物?当然是 Cheerios!(图片来源: C Coker, Cichewicz Lab) 最终,这取决于每种真菌正在进行的化学反应,以帮助我们确定它是否具有可能有助于治疗疾病的“好”的东西。我们在它们最喜欢的食物——Cheerios 早餐麦片上种植真菌。事实证明,Cheerios 不仅是婴儿、儿童和成人的绝佳食物,真菌也非常喜欢它们。我们将 Cheerios 放入试管中,与真菌一起生长数周,让它消耗麦片。然后提取真菌以去除其特殊化合物(天然产物),并将这些化合物储存在冰箱中以备后续测试。一种一种地,真菌化合物会被测试其生物活性,这些活性可能在治疗环境中很有用。例如,我们将化合物添加到癌细胞中,看看是否能阻止它们分裂,或者将它们给予致病细菌,试图阻止它们的生长。这些化合物还会被输入一个收藏品,当新的疾病靶点可用时,就会对其进行测试。生长真菌和提取化合物需要大约两个月,但由我们的生物学团队进行的测试可能只需要几天,也可能需要长达数年才能完成。第六步:纯化化合物并确定其化学结构 为了弄清楚真菌在制造什么,我们在含有 Cheerios 的大袋子里种植它们。然后,我们使用化学技术将所需的天然产物从真菌细胞中的所有其他化合物中分离出来。然后进行化学结构测定。这一步有点像解一个大谜题,我们试图弄清楚未知物质的化学成分。这是一个高度可变的步骤,可能需要几周,有时甚至需要几个月才能完成。确定未知化合物的结构很有趣,但这需要极大的耐心和我们实验室化学家的辛勤工作。

在实验室中针对疾病模型测试天然化合物(图片来源:C Coker, Cichewicz Lab)第六步:进一步测试纯化的天然产物 我们研究这些化合物的生物学用途,并将它们与我们的合作者分享,其中许多人是经过癌症和传染病生物学培训的药理学家。我们与来自全国各地的优秀科学家网络合作,试图确定这些真菌的许多新化合物的最佳用途。这一步可能需要几年时间才能完成,但好消息是,我们有许多敬业的科学家随时准备并热衷于测试来自真菌的新奇化合物。当您考虑到一旦您,我们公民科学家团队的一员,迈出了发送土壤样本的第一小步后,展开的漫长而复杂的事件链,这确实令人惊叹。您永远不知道我们可能会发现什么,或者在哪里发现它。尽管存在所有这些不确定性,但有一件事是不可否认的——没有您,我们就无法希望战胜癌症和感染等疾病。所以,不要再犹豫一秒钟了;今天就申请您的公民科学土壤采集套件,加入这场战斗。或者,正如我们所说的,“亲自动手。有所作为。”